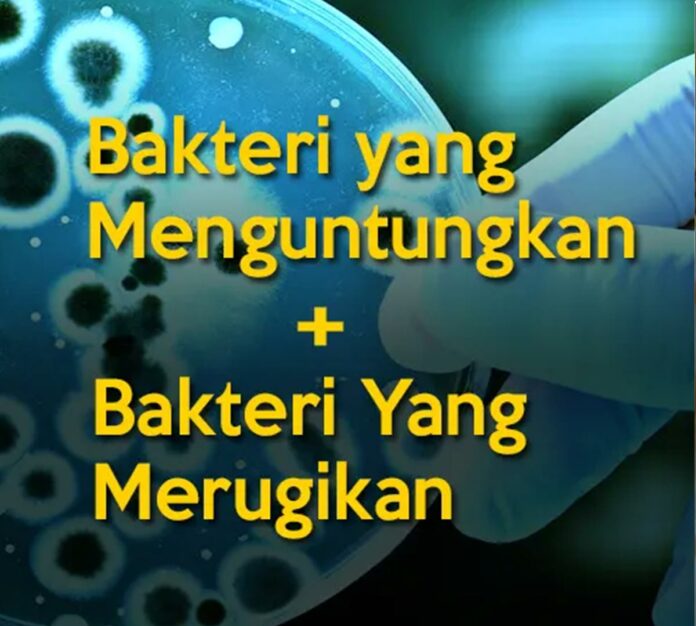

Di tengah pemahaman kita yang semakin mendalam mengenai ekosistem, peran bakteri sering kali menjadi perhatian yang kurang diperhatikan. Meskipun bakteri seringkali diasosiasikan dengan penyakit atau penguraian, sebenarnya banyak di antara mereka yang memiliki kontribusi penting bagi lingkungan. Dalam artikel ini, kita akan mengeksplorasi “10 Nama Bakteri yang Menguntungkan dan Merugikan Lingkungan”, suatu ulasan yang dapat memberikan wawasan lebih luas tentang bagaimana mikroorganisme ini berperan dalam ekosistem kita. Mari kita mulai dengan memahami bahwa tidak semua bakteri memiliki dampak negatif; ada juga yang sangat bermanfaat bagi keberlangsungan hidup berbagai organisme di bumi.
- Bacillus thuringiensis: Bakteri ini sering digunakan sebagai pestisida alami dalam pertanian. Ia menghasilkan toksin yang mematikan bagi larva serangga tertentu, sehingga membantu mengontrol hama tanpa merusak lingkungan secara signifikan.
- Rhizobium: Merupakan bakteri pengikat nitrogen yang hidup dalam simbiosis dengan akar tanaman tertentu, seperti kacang-kacangan. Mereka membantu meningkatkan kesuburan tanah dengan mengubah nitrogen atmosfer menjadi bentuk yang dapat digunakan oleh tanaman.
- Deinococcus radiodurans: Dikenal sebagai “bakteri super”, D. radiodurans mampu bertahan dalam kondisi ekstrem, termasuk radiasi tinggi. Ia memiliki potensi dalam bioremediasi, membantu dalam membersihkan lingkungan yang terkontaminasi.
- Lactobacillus: Termasuk dalam kelompok probiotik, bakteri ini bermanfaat dalam pengolahan makanan dan keseimbangan mikroflora usus. Mereka dapat berkontribusi pada kesehatan manusia dan hewan serta proses fermentasi yang meningkatkan kualitas makanan.
- Pseudomonas aeruginosa: Meskipun dikenal sebagai patogen, bakteri ini memiliki kemampuan luar biasa dalam bioremediasi. Ia mampu memecah berbagai senyawa berbahaya di lingkungan, meskipun perhatian harus diberikan pada potensi infeksinya pada manusia.
- Acidobacteria: Suatu kelompok bakteri yang merespons dan membantu penguraian bahan organik di tanah, berkontribusi pada siklus nutrisi yang sehat, dan memainkan peran penting dalam ekosistem tanah.
- Escherichia coli (E. coli) tertentu: Sebagian besar varietas E. coli bersifat tidak berbahaya dan merupakan bagian normal dari mikrobiota usus manusia. Beberapa varian bahkan dapat berkontribusi pada kesehatan pencernaan dan produksi vitamin tertentu.
- Streptomyces: Dikenal sebagai sumber antibiotik dan agen biokontrol, bakteri ini dapat mengendalikan patogen tanaman serta membantu dalam penguraian bahan organik, yang mendukung kesuburan tanah.
- Mycobacterium vaccae: Bakteri ini terdapat di tanah dan telah terbukti meningkatkan mood serta sistem kekebalan tubuh. Ia juga dapat membantu dalam mengurangi stres dan kecemasan, memberikan dampak positif pada kesehatan mental manusia.
- Clostridium perfringens: Meskipun tidak semuanya bermanfaat, beberapa jenis Clostridium dapat memicu kondisi lingkungan yang merugikan, seperti penumpukan gas beracun di tempat pembuangan sampah atau daerah yang terdegradasi.
Terdapat banyak sekali jenis bakteri, yang masing-masing memiliki peran spesifik dalam lingkungan kita. Bakteri menguntungkan dapat memberikan manfaat yang luar biasa, tidak hanya bagi ekosistem tetapi juga untuk kesehatan kita. Namun, penting juga untuk menyadari bahwa beberapa jenis bakteri dapat memberikan dampak negatif, terutama jika tidak ada pengendalian yang baik terhadap keberadaannya.
Pemahaman yang lebih baik tentang hubungan antara bakteri dan lingkungan dapat membantu kita memanfaatkan yang baik sementara mengendalikan yang berpotensi merugikan. Dalam konteks ini, ilmu pengetahuan dan teknologi memainkan peran penting dalam memanfaatkan bakteri untuk aplikasi ramah lingkungan, seperti dalam pertanian berkelanjutan dan pengolahan limbah.
Secara keseluruhan, eksplorasi terhadap kedua sisi bakteri – yaitu yang menguntungkan dan merugikan – mengajak kita untuk lebih bijak dalam menangani keberagaman mikroorganisme ini. Melalui pendekatan yang tepat, kita dapat memaksimalkan manfaat bakteri yang menguntungkan sekaligus meminimalkan risiko dari yang merugikan. Dengan demikian, keberlanjutan lingkungan dapat terjaga, dan kualitas hidup kita sebagai bagian dari ekosistem ini pun dapat meningkat.